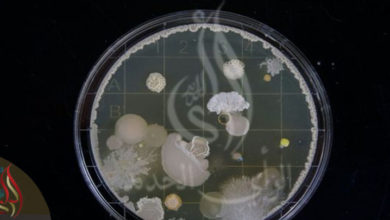

ناسا
-
5.متفرقات

خزان مياه عملاق بحجم محيطات.. دراسة جديدة عن مكان المياه في المريخ
نيويورك ــ الرأي الجديد كشفت وكالة “ناسا” عن دليل على وجود خزان جوفي من المياه في أعماق سطح كوكب المريخ، وفقًا لدراسة…
أكمل القراءة » -
5.متفرقات

وفاة رائد الفضاء وليام أندرس في حادث تحطم طائرة
واشنطن ــ الرأي الجديد توفي رائد الفضاء المتقاعد وليام أندرس، الذي كان أحد أول ثلاثة أشخاص داروا حول القمر والتقط…
أكمل القراءة » -
أحداث
روّاد فضاء يكتشفون نوعا جديدا من “البكتيريا” قادرة على محو البشرية بأكملها … وأطباء يعلّقون: “ستحدث كارثة” !
تونس ــ الرأي الجديد (مواقع) اكتشف روّاد الفضاء، نوعا جديدا من البكتيريا في محطة الفضاء الدولية، وصفت بأنها “شرسة للغاية…
أكمل القراءة » -
1.المشهد الثقافي

قارة كاملة “ستغرق في الظلام”: كسوف “كلّي” للشمس يقترب
تونس ــ الرأي الجديد (مواقع) من المنتظر، أن يحجب القمر، الشمس، تماما عن ملايين الأشخاص في أمريكا الشمالية على طول…
أكمل القراءة » -
5.متفرقات

“ناسا” تعلن اكتشاف الماء والكربون في عينات جلبتها من كويكب “بينو”
الرأي الجديد (قسم المتابعات) كشفت وكالة “ناسا” عن عينات جلبها علماء من كويكب غني بالكربون والماء، يطلق عليه “بينو”، وهو…
أكمل القراءة » -
1.المشهد الثقافي

“كويكب” كبير يمرّ أمام الأرض غدا
تونس ــ الرأي الجديد (وكالات) من المنتظر، أن يمرّ كويكب يحمل إسم “2023 جيه كيه” بسرعة أمام الأرض غدا الأحد.…
أكمل القراءة » -
1.المشهد الثقافي

كويكب “2023 جي د2” يمرّ من مسافة قريبة من الأرض … فهل يشكّل “خطورة” ؟
تونس ــ الرأي الجديد أكدت رئيسة مصلحة فضاء الكون بمدينة العلوم بتونس، سارة السنوسي، أن الكويكب”2023 جي د2″، الذي خرج…
أكمل القراءة » -
5.متفرقات

تسجيل أول “توهّج” شمسي قويّ في العام الجديد
تونس ــ الرأي الجديد قالت الجمعية التونسية لعلوم الفلك، أن الأقمار الصناعية المخصّصة لمراقبة الشمس، سجّلت، أمس، أول توهج شمسي…
أكمل القراءة » -
5.متفرقات

الشمس تبتسم .. و”الناسا” تفسر هذه الظاهرة
واشنطن ــ الرأي الجديد (وكالات) شغلت صورة للشمس مواقع التواصل الاجتماعي وأقلقت الخبراء رغم منظرها الجميل والودود. فقد التقط قمر…
أكمل القراءة » -
5.متفرقات

زلزال هو الأقوى كونيا… إكتشاف مثير على الكوكب الأحمر
واشنطن ــ الرأي الجديد (وكالات) كشفت إدارة الطيران والفضاء الأميركية “ناسا”، أن الصور التي التقطها مسبار “إنسايت” لحفرة ضخمة في…
أكمل القراءة »
